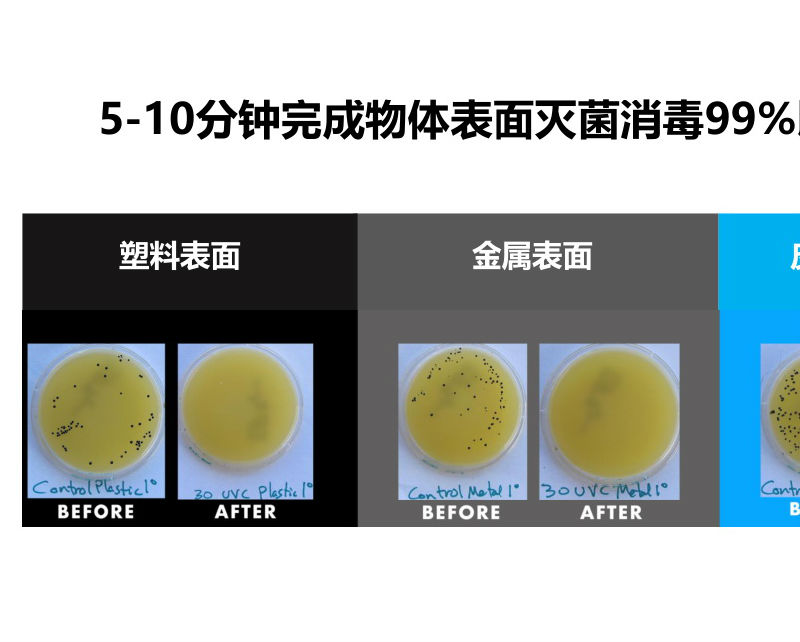

熱門關(guān)鍵詞: 美國Bray博雷閥門 Lowara水泵 美國Tuthill風機 美國Spencer風機 德國sika儀表
熱門關(guān)鍵詞: 美國Bray博雷閥門 Lowara水泵 美國Tuthill風機 美國Spencer風機 德國sika儀表

機器人滅菌消毒解決方案介紹(紫外線消毒車)
紫外智能消毒機器人適合應用場景:
* 公共場所:醫(yī)院、養(yǎng)老院、殯儀館、圖書館、政務大廳等
* 交通工具:動車、飛機、公交等
紫外智能消毒機器人的組成單元:
1、以自主移動機器人作為移動載體
?無人駕駛、自動規(guī)劃路徑、自主導航、自主避障
? AI機器視覺,先進的識別技術(shù)
?自主移動:3重避障和防撞技術(shù)
?移動機器人平臺
2、AI技術(shù)
?不依賴于網(wǎng)絡的本地識別
? AI視覺技術(shù)進行活體判斷
?強大的工程化能力
?運行于ARM平臺
?全自主算法
? SLAM導航定位
?低速無人駕駛技術(shù)
?多傳感器融合技術(shù)
? 圖像識別分類
3、環(huán)境感知
* 快速識別與多激光雷達和360o超聲波傳感器
? 機器人群控技術(shù)
? 具備活體自動識別功能與自動關(guān)閉紫外照射功能
* 紫外線燈管滅菌消毒單元
? UVC紫外線(254nm)照射
? 360o無死角高效滅菌消毒
紫外線主要通過對微生物(包括細菌、病毒、芽孢等病原體)的輻射以損傷和破壞核酸DNA的功能使微生物致死,從而達到消毒目的。
?消殺細菌和病毒:金黃色葡萄球菌、白色葡萄球菌、銅綠假單胞菌、大腸桿菌、 肺炎克雷伯菌、 白色假絲酵母菌 等。
?為達到殺菌消毒效果,紫外燈照射強度應不低于70μW/cm2,一般每7~10m2須固定安裝一支30W的紫 外線燈,消毒有效距離2米以內(nèi)。
4、智能控制系統(tǒng)
?機器人、滅菌消毒單元及環(huán)境三者實時聯(lián)動
?消毒模式、消毒時間、消毒效果評估智能化控制
紫外智能消毒機器人配置規(guī)格說明
?機身尺寸:530*508*1608毫米
?移動速度:0.5-1.2米/秒
?導航精度:3-5厘米
?紫外燈管:15W*12根
?紫外波長:254nm
?單點消毒時間: 5-10分鐘
?持續(xù)工作時間:4-6小時
?操作方式:電腦、手機、PAD
?資質(zhì)認證:CE認證、ISO9001
紫外智能消毒機器人技術(shù)特點
自主導航與規(guī)劃:激光精確掃描地圖,根據(jù)地圖進行實時導航,實現(xiàn)對空間的記憶、規(guī)劃與消毒,全自主算法與多模式室內(nèi)無人駕駛。
自動檢測與避障:多激光雷達、360°超聲波傳感器感知障礙物,可自行向前或向后行走, 適于狹窄空間;自動檢測評估消毒效果。
環(huán)境與人員安全保障:AI活體檢測,防止人員入侵和保障人員安全;使用WIFI開關(guān)門、控制和使用電梯、與環(huán)境實現(xiàn)自我交互;符合《醫(yī)療機構(gòu)消毒技術(shù)規(guī)范》WS/T367中A.3.1.2規(guī)定,紫外線消毒燈符合GB19258國家標準。
智能操作與高效運行:操作簡便,減少培訓時間,無需人員陪伴;自動采集數(shù)據(jù),進行數(shù)據(jù)實時跟蹤和分析,實現(xiàn)自我優(yōu)化。
無化學污染,降低物體表面腐蝕風險!
上海煜柯銷售紫外智能消毒機器人(消殺機器人),提供各類機器人(紫外線消毒車)解決方案,歡迎來電咨詢。